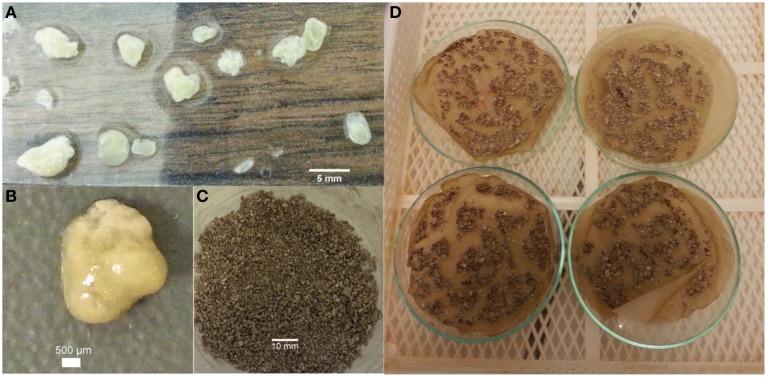
https://cdn.ncbi.nlm.nih.gov/pmc/blobs/2a90/4631954/10f743c57f45/fmicb-06-01228-g0001.jpg

用于混凝土裂缝内部修复的自保护型硝酸盐还原培养物。
Self-protected nitrate reducing culture for intrinsic repair of concrete cracks.
作者信息
Erşan Yusuf Ç, Gruyaert Elke, Louis Ghislain, Lors Christine, De Belie Nele, Boon Nico
机构信息
Laboratory of Microbial Ecology and Technology, Department of Biochemical and Microbial Technology, Ghent University Ghent, Belgium ; Magnel Laboratory for Concrete Research, Department of Structural Engineering, Ghent University Ghent, Belgium.
Magnel Laboratory for Concrete Research, Department of Structural Engineering, Ghent University Ghent, Belgium.
出版信息
Front Microbiol. 2015 Nov 4;6:1228. doi: 10.3389/fmicb.2015.01228. eCollection 2015.
Attentive monitoring and regular repair of concrete cracks are necessary to avoid further durability problems. As an alternative to current maintenance methods, intrinsic repair systems which enable self-healing of cracks have been investigated. Exploiting microbial induced CaCO3 precipitation (MICP) using (protected) axenic cultures is one of the proposed methods. Yet, only a few of the suggested healing agents were economically feasible for in situ application. This study presents a [Formula: see text] reducing self-protected enrichment culture as a self-healing additive for concrete. Concrete admixtures Ca(NO3)2 and Ca(HCOO)2 were used as nutrients. The enrichment culture, grown as granules (0.5-2 mm) consisting of 70% biomass and 30% inorganic salts were added into mortar without any additional protection. Upon 28 days curing, mortar specimens were subjected to direct tensile load and multiple cracks (0.1-0.6 mm) were achieved. Cracked specimens were immersed in water for 28 days and effective crack closure up to 0.5 mm crack width was achieved through calcite precipitation. Microbial activity during crack healing was monitored through weekly NOx analysis which revealed that 92 ± 2% of the available [Formula: see text] was consumed. Another set of specimens were cracked after 6 months curing, thus the effect of curing time on healing efficiency was investigated, and mineral formation at the inner crack surfaces was observed, resulting in 70% less capillary water absorption compared to healed control specimens. In conclusion, enriched mixed denitrifying cultures structured in self-protecting granules are very promising strategies to enhance microbial self-healing.
对混凝土裂缝进行细致监测并定期修复,对于避免进一步的耐久性问题十分必要。作为当前维护方法的替代方案,能够实现裂缝自愈的内在修复系统已得到研究。利用(受保护的)无菌培养物诱导微生物碳酸钙沉淀(MICP)是其中一种被提出的方法。然而,在原位应用中,只有少数几种建议的愈合剂在经济上是可行的。本研究提出一种还原型自保护富集培养物作为混凝土的自愈添加剂。混凝土外加剂硝酸钙(Ca(NO3)2)和甲酸钙(Ca(HCOO)2)被用作营养物质。将以颗粒形式(0.5 - 2毫米)生长的富集培养物添加到砂浆中,该颗粒由70%的生物质和30%的无机盐组成,且无需任何额外保护。养护28天后,对砂浆试件施加直接拉伸载荷,形成了多条裂缝(0.1 - 0.6毫米)。将有裂缝的试件浸泡在水中28天,通过方解石沉淀实现了高达0.5毫米裂缝宽度的有效裂缝闭合。通过每周的氮氧化物分析监测裂缝愈合过程中的微生物活性,结果表明92±2%的可用被消耗。另一组试件在养护6个月后开裂,从而研究了养护时间对愈合效率的影响,并观察到裂缝内表面的矿物形成,与愈合的对照试件相比,毛细吸水率降低了70%。总之,以自保护颗粒形式构建的富集混合反硝化培养物是增强微生物自愈能力的非常有前景的策略。